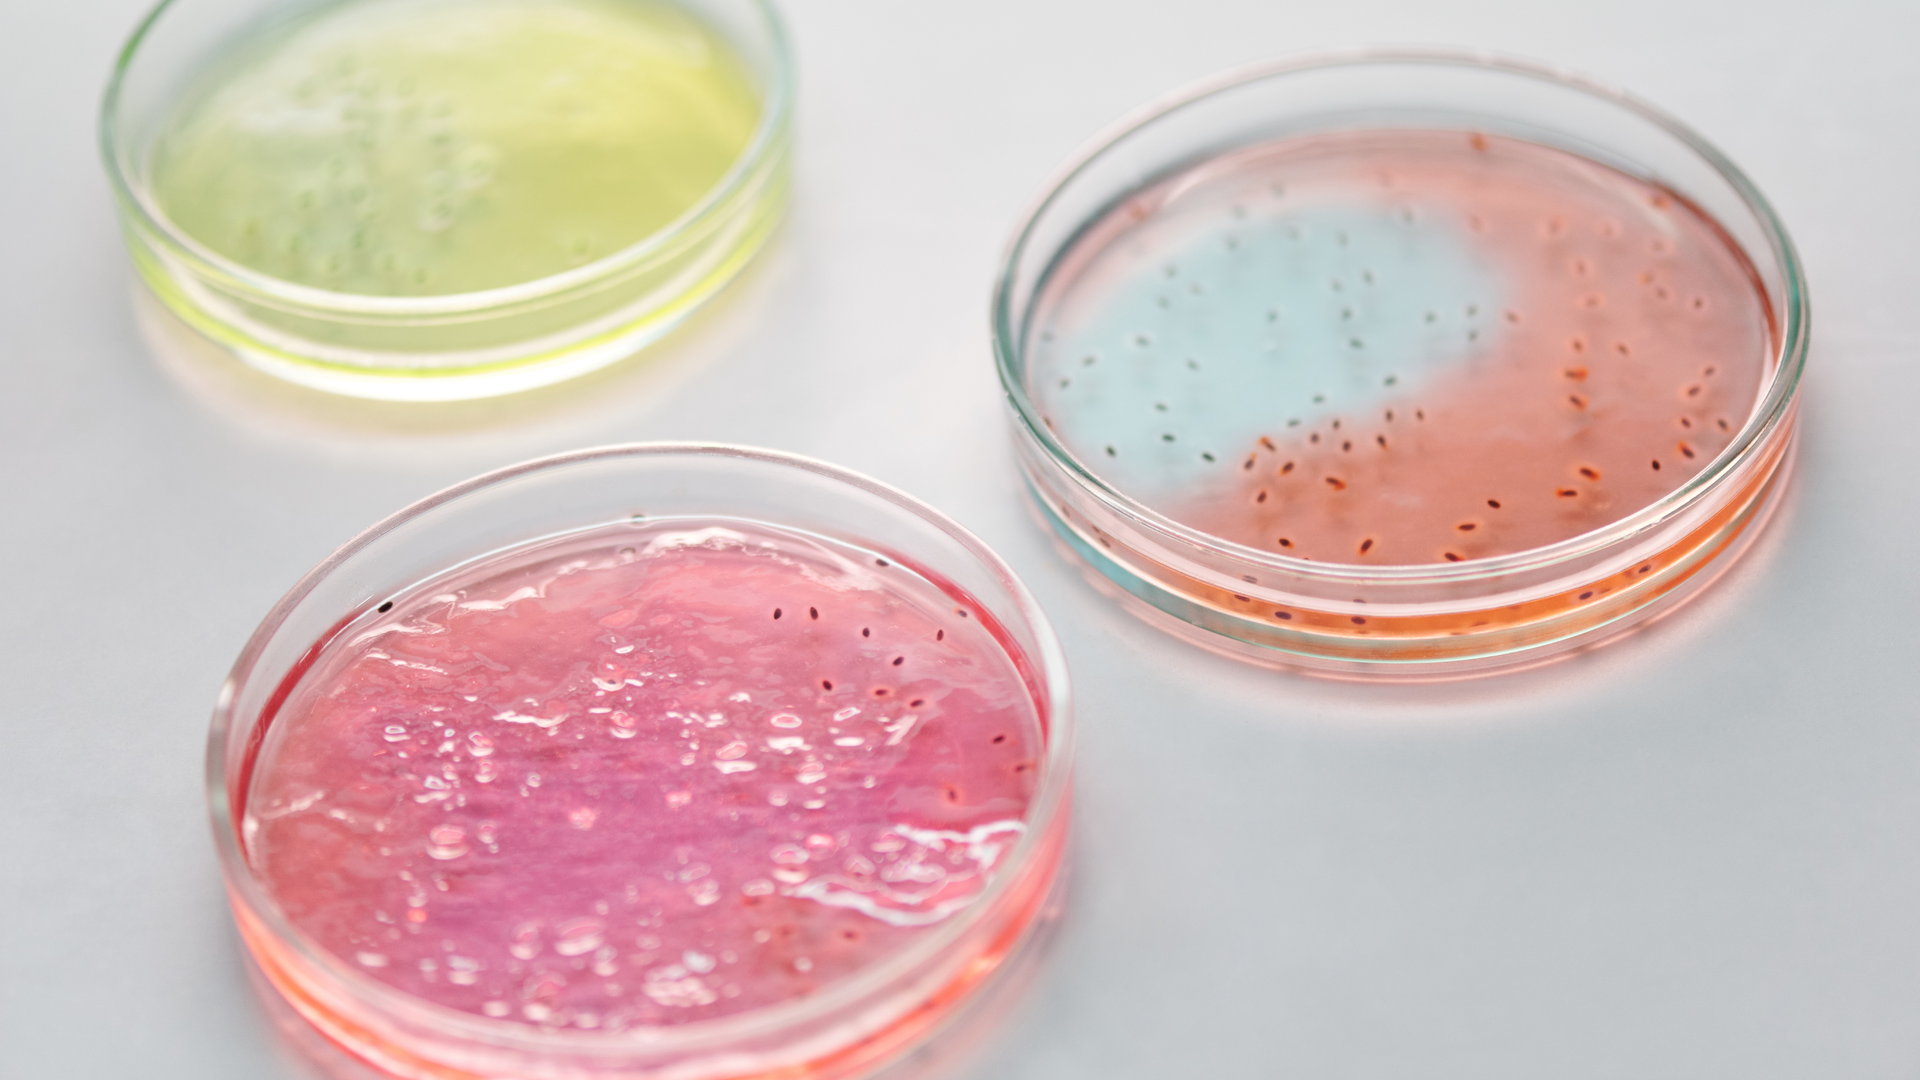
Photo by Edward Jenner from Pexels

Cleveland Clinic identifies connection between gut microbes and stroke
New findings from Cleveland Clinic researchers show for the first time that the gut microbiome impacts stroke severity and functional impairment following stroke, announced the clinic. The results, published in Cell Host & Microbe, lay the groundwork for potential new interventions to help treat or prevent stroke.
The research was led by Weifei Zhu, Ph.D., and Stanley Hazen, M.D., Ph.D., of Cleveland Clinic’s Lerner Research Institute. The study builds on more than a decade of research spearheaded by Dr. Hazen and his team related to the gut microbiome’s role in cardiovascular health and disease, including the adverse effects of TMAO (trimethylamine N-oxide) - a byproduct produced when gut bacteria digest certain nutrients abundant in red meat and other animal products.
“In this study we found that dietary choline and TMAO produced greater stroke size and severity, and poorer outcomes in animal models,” said Dr. Hazen, chair of the Department of Cardiovascular & Metabolic Sciences and director of Cleveland Clinic’s Center for Microbiome & Human Health. “Remarkably, simply transplanting gut microbes capable of making TMAO was enough to cause a profound change in stroke severity.”
Previously, Dr. Hazen and his team discovered that elevated TMAO levels can lead to the development of cardiovascular disease. In clinical studies involving thousands of patients, they have shown that blood levels of TMAO predict future risk of heart attack, stroke and death -findings that have been replicated around the world. Earlier studies, also led by Drs. Zhu and Hazen, were the first to show a link between TMAO and enhanced risk for blood clotting.
“This new study expands on these findings, and for the first time provides proof that gut microbes in general - and through TMAO specifically - can directly impact stroke severity or post-stroke functional impairment,” said Dr. Hazen.
The researchers compared brain damage in preclinical stroke models between those with elevated or reduced TMAO levels. Over time, those with higher levels of TMAO had more extensive brain damage and a greater degree of motor and cognitive functional deficits following stroke. The researchers found that dietary changes that alter TMAO levels, such as eating less red meat and eggs, impacted stroke severity. The team also found that a gut microbe enzyme critical to TMAO production called CutC drove heightened stroke severity and worsened outcomes.
According to Dr. Zhu, targeting this gut microbe enzyme may be a promising approach to prevent stroke.
“When we genetically silenced the gut microbe gene that encodes CutC, stroke severity significantly diminished,” she said. “Ongoing research is exploring this treatment approach, as well as the potential for dietary interventions to help reduce TMAO levels and stroke risk, since both a Western diet and a diet rich in red meat are known to elevate TMAO levels. Switching to plant-based protein sources helps to lower TMAO.”
The study was supported in part by the National Heart, Lung, and Blood Institute.